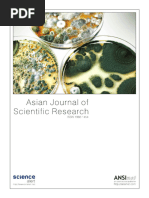

RESOURCES MANAGMENT
Resource Management:
Resource :An item that is used by a consumer
Resource Management: Ensure utilization of such resources
Service provider leases such resources to the consumer
Different types of resources
Different ways of provisioning such resources in cloud.
Resource Types:
1. Computer Resources:
Collection of physical machines
Processors, memory, network interface, I/O
Provides the computational capacity of cloud
2. Network Resources: With a data center, large number of compute resources are
clustered and interconnected using high bandwidth network.
3. Power Resources:
Data center consumes large amount of power.
Creating and reducing the power consumption is the focus
Different Roles
Different Service providers: Provide hardware and software equipment and
solution for cloud users. Need to have a wealth of software, hardware and industry
experience.
1
� Enterprise users: many small and medium enterprise are users in the cloud
computing industrial chain. Can rent or build a small private cloud.
Individual users: individual user will use services mainly through thin clients,
mobil handsets and other devices.
Commercial Cloud: open source cloud platforms have been widely applied in the
industry.
Resource Management:
Process of allocating computing storage, networking and energy resources.
Meet the performance objectives
Application’s
Service providers
Service consumers
Scheduling in Resource Management:
For any system scheduling of resources is at the core.
Cloud computing is no exception.
Advanced and optimized resource scheduling is needed.
An improved scheduling improves efficiency of the system.
Improves sharing of resources. performance and reduce operating.
Scheduling in Cloud:
Scheduling in cloud is hander than many other systems.
In cluster, centralized scheduler enhances the overall system performance.
In grid system distribute scheduler enhance the performance of end users.
Scheduling in cloud is not this simple
We require a centralized Scheduler
In a datacenter.
We need a distributed Scheduler
Customers are distributed worldwide.
Scheduling issues:
Scheduling in cloud has to cope with many issues:
Allocation of many small requests
Workload characterization
Type of request
Allocations are real-time and no provision for queuing
2
�Scheduling Types:
Resources Scheduling is a process of allocating resources from resource providers
to users.
In cloud ,there are generally two levels of Scheduling:
Job Scheduling and
Task Scheduling
There are various names that are given for these two levels and semantics of the
Scheduling may slightly differ.
Job Scheduling:
Job level Scheduling is a user specific operation ,the system is assigned specific jobs
Some require more computing resources.
High performance parallel processing procedures.
Each job has to be scheduled based on the demand.
Job Scheduling has various names:
User level Scheduling
Global Scheduling
Job Schedulers:
Job Scheduling may vary depending on criteria:
Market based Scheduling
Commodity and posted price models
Auction based Scheduling
Spot instance of Amazon
Economic Scheduler
3
�Task Scheduling:
Task Scheduling refers primary to the underlying infrastructure resources as a
service (IAAS) available to tasks.
CPU, memory and network bandwidth, VMs (including virtual CPU, memory and
network bandwidth), and virtual clustering are types of infrastructure computing
resources.
Task Scheduling has various names:
System level Scheduling
Local Scheduling
Facility level Scheduling
Task Schedulers
Typically task Scheduling is performed using heuristic models .
There are:
Static
Two assumptions: all arrive together and available time is updated after
each task is scheduled.
Minimum completion time
Min-Min
GA
Dynamic
Neither task set or machine set is fixed
Sufferage
Heuristic Schedulers
Many data intensive jobs in cloud
Hadoop
FIFO Scheduler
Fair Scheduler
Capacity Scheduler
Delay Scheduler
Dryad
Quincy
Resource Management
Resource management (RM) has other functionalities besides Scheduling.
Let us take a look at all of these:
Global Scheduling
Resource Demand Profiling
Resource utilization estimation
4
� Resource pricing and profit maximization
Local Scheduling
Application Scaling and provisioning
Workload management
Cloud management system.
Global Scheduling
Global Scheduling involves a system wide perspective on the allocation of the
physical and virtualized resources that comprise a cloud environment.
There can be two types of controllers:
i. Centralized resource controller: the controller have full control of the
allocation of a given set of resources.
ii. Decentralized resource controllers:
Concerns in Global Scheduling:
Dynamic virtual machine placement and provisioning.
Network aware virtual machine placement.
Energy aware virtual machine placement.
Resource Demand profiling:
In cloud the workload of applications varies dynamically over multiple time scales.
Demand profiling for resource aim to predict the variation.
Two broad approaches :
i. Model driven: A pre identified application model is used to profile demand
ii. Model free: Statistical forecasting techniques are used to make
predictions on future workload intensity.
Resource utilization Estimation:
To manage resources, accurate estimations of the state of the physical and
virtualized resources are needed.
Estimate the utilization for compute, network, storage and power resources.
Two reasons for such assessment:
5
� How much free resources are available in the system
For profiling the resource utilization patterns of individual workload.
Local Scheduling:
Local Scheduling of virtualized resources:
Tasks belonging to different users are not distinguishable in this layer.
Essentially this is a matching problem:
Matching multiple tasks to multiple machines.
Work Load Management:
Application usage sessions processed using cloud resources are the workload.
Various aspects are to be considered for workload management.
Some of the important one are:
i. Load balancing
ii. Workload management
Storage resource
Geo-distributed cloud
Cloud Management System:
CMS provides an interface for human administrators
Reporting and command and control
Define management metrics
Provide a standard on assessing the operation of the resource management
system.
Essentially to monitor the degree to which the system meets its SLAS.
Cloud Resources
Cloud Resources: software networks to dynamically allocate resources and run
applications for remote end users.
Typically divided into three categories (private, public and hybrid) cloud
developments have grown rapidly in recent years, promising cost saving and
flexibility over traditional private data centers.
Virtualization is key for cloud computing .By allowing physical server to run one
or more virtual machines on demand, cloud architectures offer rapid scaling and
efficient allocation of server resources on the fly.
Private cloud refers to cloud infrastructure dedicated to a single company and
accessed by a private network connection, operating on server managed either
internally or by a third party provider.
For many organizations in highly regulated industries, private clouds remain the
solution of choice.
6
� Cloud infrastructure platforms such as open stack offer a framework for private
cloud deployment and management, and a bevy of vendors have begun relating
supported versions of the open source platform.
The public cloud refers to services such as Amazon Web services, which sell
server resources (rather than dedicated physical server) accessed over a public
network such as the internet.
Hybrid cloud (sometimes called “cloud bursting”) is the combination of multiple
clouds.
For example, a company cloud use public cloud services to handle temporary
bursts of activity that exceed private cloud capacity.
Some companies also use private clouds for certain sensitive business units while
hosting less critical application on the public cloud.
_____________________________________________________________________________________